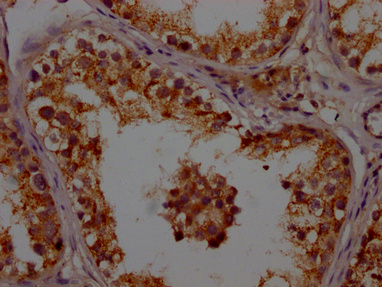

APOO Antibody
-
中文名稱:APOO兔多克隆抗體
-
貨號:CSB-PA001948LA01HU
-
規格:¥440
-
圖片:
-
IHC image of CSB-PA001948LA01HU diluted at 1:200 and staining in paraffin-embedded human testis tissue performed on a Leica BondTM system. After dewaxing and hydration, antigen retrieval was mediated by high pressure in a citrate buffer (pH 6.0). Section was blocked with 10% normal goat serum 30min at RT. Then primary antibody (1% BSA) was incubated at 4°C overnight. The primary is detected by a Goat anti-rabbit polymer IgG labeled by HRP and visualized using 0.05% DAB.
-
-
其他:
產品詳情
-
產品名稱:Rabbit anti-Homo sapiens (Human) APOO Polyclonal antibody
-
Uniprot No.:
-
基因名:APOO
-
別名:APOO; FAM121B; MIC23; MIC26; My025; UNQ1866/PRO4302; MICOS complex subunit MIC26; Apolipoprotein O; MICOS complex subunit MIC23; Protein FAM121B
-
宿主:Rabbit
-
反應種屬:Human
-
免疫原:Recombinant Human MICOS complex subunit MIC26 protein (26-198AA)
-
免疫原種屬:Homo sapiens (Human)
-
標記方式:Non-conjugated
本頁面中的產品,APOO Antibody (CSB-PA001948LA01HU),的標記方式是Non-conjugated。對于APOO Antibody,我們還提供其他標記。見下表:
-
克隆類型:Polyclonal
-
抗體亞型:IgG
-
純化方式:>95%, Protein G purified
-
濃度:It differs from different batches. Please contact us to confirm it.
-
保存緩沖液:Preservative: 0.03% Proclin 300
Constituents: 50% Glycerol, 0.01M PBS, PH 7.4 -
產品提供形式:Liquid
-
應用范圍:ELISA, IHC
-
推薦稀釋比:
Application Recommended Dilution IHC 1:200-1:500 -
Protocols:
-
儲存條件:Upon receipt, store at -20°C or -80°C. Avoid repeated freeze.
-
貨期:Basically, we can dispatch the products out in 1-3 working days after receiving your orders. Delivery time maybe differs from different purchasing way or location, please kindly consult your local distributors for specific delivery time.
-
用途:For Research Use Only. Not for use in diagnostic or therapeutic procedures.
相關產品
靶點詳情
-
功能:Component of the MICOS complex, a large protein complex of the mitochondrial inner membrane that plays crucial roles in the maintenance of crista junctions, inner membrane architecture, and formation of contact sites to the outer membrane. Plays a crucial role in crista junction formation and mitochondrial function. Can promote cardiac lipotoxicity by enhancing mitochondrial respiration and fatty acid metabolism in cardiac myoblasts. Promotes cholesterol efflux from macrophage cells. Detected in HDL, LDL and VLDL. Secreted by a microsomal triglyceride transfer protein (MTTP)-dependent mechanism, probably as a VLDL-associated protein that is subsequently transferred to HDL.
-
基因功能參考文獻:
- The human apolipoprotein MIC26 is a bona fide subunit of the MICOS complex. PMID: 25764979
- It is likely that apoO participates in fatty acid metabolism and the inflammatory response in HepG2 cells. PMID: 24341743
- APOO represents a link between impaired mitochondrial function and cardiomyopathy onset, and targeting APOO-dependent metabolic remodeling has potential as a strategy to adjust heart metabolism and protect the myocardium from impaired contractility. PMID: 24743151
- relationships between plasma apoO levels and high-sensitive C-reactive protein (hs-CRP) levels, as well as other lipid parameters in healthy subjects and patients with established acute coronary syndrome PMID: 22693255
- apolipoprotein O is the first chondroitin sulfate chain containing apolipoprotein PMID: 16956892
顯示更多
收起更多
-
亞細胞定位:Mitochondrion inner membrane; Single-pass membrane protein. Secreted. Mitochondrion. Golgi apparatus membrane. Endoplasmic reticulum membrane.
-
蛋白家族:Apolipoprotein O/MICOS complex subunit Mic27 family
-
組織特異性:Expressed in all tissues examined. Up-regulated in diabetic heart.
-
數據庫鏈接:
Most popular with customers
-
-
YWHAB Recombinant Monoclonal Antibody
Applications: ELISA, WB, IHC, IF, FC
Species Reactivity: Human, Mouse, Rat
-
Phospho-YAP1 (S127) Recombinant Monoclonal Antibody
Applications: ELISA, WB, IHC
Species Reactivity: Human
-
-
-
-
-